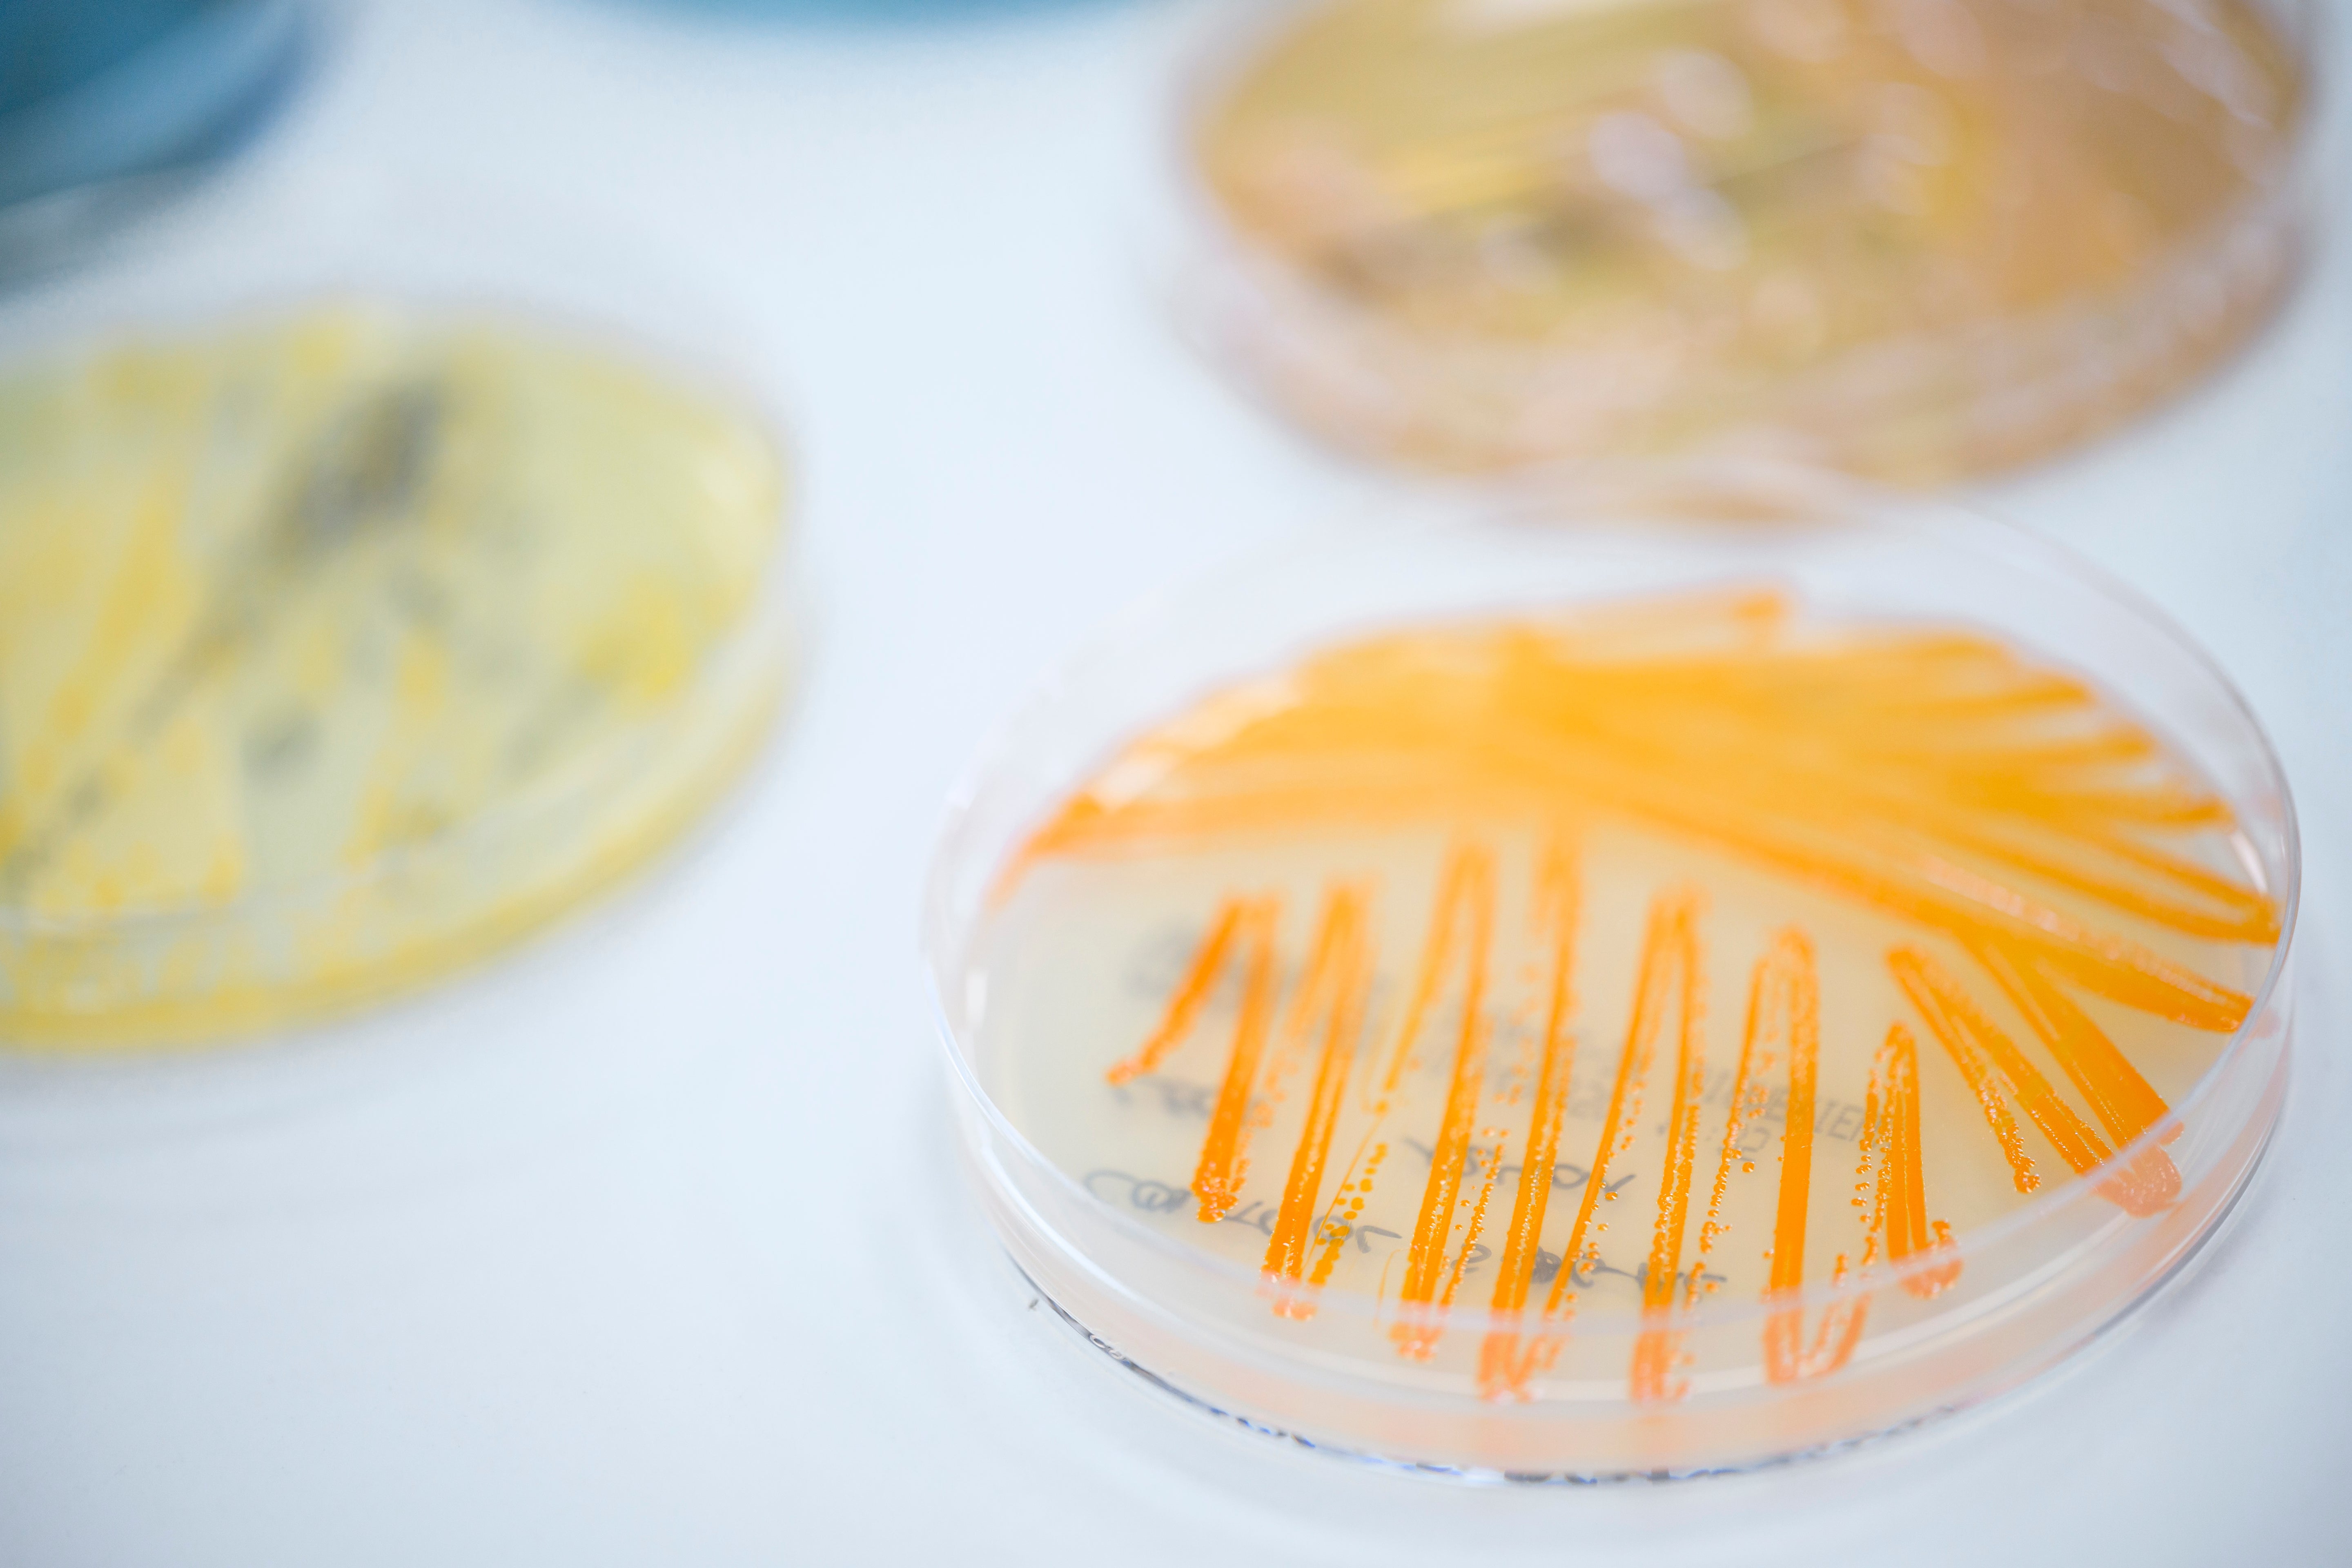

Tècniques Analítiques
- Cultius
- Sistema automàtic hemocultius
- Sistema automàtic ID+ATB
- Sistema automàtic micobacteris
- Microscòpia òptica
- Sediment d’Orina
- Cultius selectius
Accions
- Bacteriologia
- Micobacteris
- Micologia
- Parasitologia
Búsquedas populares
El teu carret està buit.
Diagnostiquem malalties infeccioses mitjançant la demostració de l’agent causant d’aquestes infeccions en les mostres biològiques recollides a l’animal.
Incloem l’estudi parasitològic de mostres com sang, femtes, exsudats, etc.; amb tècniques específiques per a cada espècie parasitària.
A més, col·laborem en la realització d’estudis dissenyats per determinar la flora bacteriana existent en mostres biològiques concretes.








Ciència i tecnologia al teu servei

Diagnòstics clars i fiables

Experiència que marca la diferència
